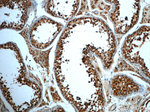
TMF1 Antibody in Immunohistochemistry (Paraffin) (IHC (P))

Search
Proteintech
TMF1 Polyclonal Antibody
{{$productOrderCtrl.translations['antibody.pdp.commerceCard.promotion.promotions']}}
{{$productOrderCtrl.translations['antibody.pdp.commerceCard.promotion.viewpromo']}}
{{$productOrderCtrl.translations['antibody.pdp.commerceCard.promotion.promocode']}}: {{promo.promoCode}} {{promo.promoTitle}} {{promo.promoDescription}}. {{$productOrderCtrl.translations['antibody.pdp.commerceCard.promotion.learnmore']}}
产品信息
22212-1-AP
种属反应
宿主/亚型
分类
类型
抗原
偶联物
形式
浓度
规格
纯化类型
保存液
内含物
保存条件
运输条件
产品详细信息
Immunogen sequence: GSQTSSWEK LEKNLSDRLG ESQTLLAAAV ERERAATEEL LANKIQMSSM ESQNSLLRQE NSRFQAQLES EKNRLCKLED ENNRYQVELE NLKDEYVRTL EETRKEKTLL NSQLEMERMK VEQERKKAIF TQETIKEKER KPFSVSSTPT MSRSSSISGV DMAGLQTSFL SQDESHDHSF GPMPISANGS NLYDAVRMGA GSSIIENLQS QLKLREGEIT HLQLEIGNLE KTRSIMAEEL VKLTNQNDEL EEKVKEIPKL RTQLRDLDQR YNTILQMYGE KAEEAEELRL DLEDVKNMYK TQIDELLRQS LS (783-1093 aa encoded by BC126123)
靶标信息
Adapter protein that may provide indirect link between the endocytic membrane traffic and the actin assembly machinery. May regulate the formation of clathrin-coated vesicles. Isoform 1 could be involved in brain-specific synaptic vesicle recycling.
仅用于科研。不用于诊断过程。未经明确授权不得转售。
篇参考文献 (0)
生物信息学
蛋白别名: Androgen receptor coactivator 160 kDa protein; Androgen receptor-associated protein of 160 kDa; TATA element modulatory factor; TMF; unnamed protein product
基因别名: 7030402D04Rik; ARA160; Gm153; TMF; TMF1; Tmf1`
UniProt ID: (Human) P82094, (Mouse) B9EKI3
Entrez Gene ID: (Human) 7110, (Rat) 114206, (Mouse) 232286